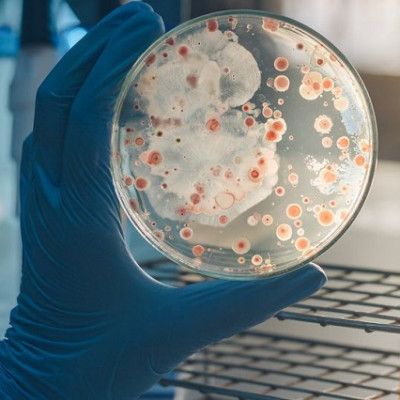
Antiviral Color Nanocoating Technology

2024-02-04
Visited : 1237
Virus elimination effect along with a wide range of colors achieved with a low coating amount of 1g/m2. Expected to be utilized in various industries such as medical materials, home appliances, building materials, etc.
Since the onset of COVID-19, we've become accustomed to seeing antiviral films attached to elevator buttons and public transportation handles. However, conventional antiviral films are made by mixing antiviral metal particles with polymers. Due to the manufacturing process, only a very small fraction of these metal particles is exposed on the surface. As a result, contrary to the belief that these films will protect us from viruses, the actual antiviral effect upon contact with the film surface is not significant.
The Korea Institute of Science and Technology (KIST) has announced that a collaborative research team led by Dr. So-Hye Cho from the Materials Architecturing Research Center and Dr. Seung Eun Lee of the Research Animal Resources Center has developed a nanocoating technology that not only maximizes the antiviral activity of the surface, but also enables the realization of various colors.
The research team has developed an effective antiviral and antibacterial surface by using the sol-gel method to form a silica coating layer on various surfaces, followed by coating the silica layer with silver (Ag) nanoparticles using an aqueous solution containing silver. In turn, silver nanoparticles limit the infectivity of viruses by binding to the proteins on the virus surface, disrupting the structure and function of the virus, and making it difficult for the virus to penetrate cells.
In conventional antiviral films, antiviral functional metal particles are embedded within the thin film, making it difficult for silver to come in contact with viruses. However, the technology developed by the KIST research team showcased remarkable activity with a small amount of silver nanoparticles positioned on the thin film's surface. Experiments involving lentiviruses, developed as analogs to coronaviruses, demonstrated a virus elimination rate more than twice as fast compared to commercial films. In addition, antibacterial tests against E. coli bacteria resulted in complete eradication of the bacteria within 24 hours. The developed antiviral coating technology also has the additional advantage of providing various colors by controlling light interference through different coating layer thickness.
"This metal nanoparticle coating technology demonstrates superior antiviral and antibacterial effects compared to commercial products, even with a small coating of less than 1 g/m2, so its industrialization potential is very high," said Dr. So-Hye Cho of KIST. "It can be used in various industries such as medical materials, home appliances, and building materials to help manage microorganisms and prevent infections by implementing antiviral and antibacterial effects."
Read the original article on EurekAlert.